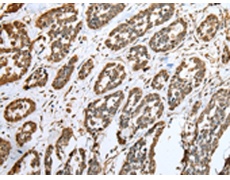
一抗

中文名稱:兔抗CNPY2多克隆抗體
|
Background: |
Positive regulator of neurite outgrowth by stabilizing myosin regulatory light chain (MRLC). It prevents MIR-mediated MRLC ubiquitination and its subsequent proteasomal degradation. |
|
Applications: |
ELISA, WB, IHC |
|
Name of antibody: |
CNPY2 |
|
Immunogen: |
Full length fusion protein |
|
Full name: |
canopy FGF signaling regulator 2 |
|
Synonyms: |
MSAP; TMEM4; ZSIG9; HP10390 |
|
SwissProt: |
Q9Y2B0 |
|
ELISA Recommended dilution: |
5000-10000 |
|
IHC positive control: |
Human esophagus cancer and human prostate cancer |
|
IHC Recommend dilution: |
25-100 |
|
WB Predicted band size: |
21 kDa |
|
WB Positive control: |
HEPG2 cell |



 購物車
購物車 幫助
幫助
 021-54845833/15800441009
021-54845833/15800441009